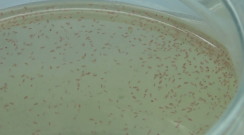

|
家でメダカの飼育を始めました。 幹之(みゆき)メダカです。 |
|
 |
水槽内の水温は23℃に保って います。 |
|
 |
タマミジンコを生きたエサ として時々与えています。 |
|
 |
タマゴから孵化した稚魚です。 | |
 |
稚魚はどんどん大きくなります。 |
メダカのページ
 |
家でメダカの飼育を始めました。 幹之(みゆき)メダカです。 |
|
 |
水槽内の水温は23℃に保って います。 |
|
|
タマミジンコを生きたエサ として時々与えています。 |
|
 |
タマゴから孵化した稚魚です。 | |
 |
稚魚はどんどん大きくなります。 |